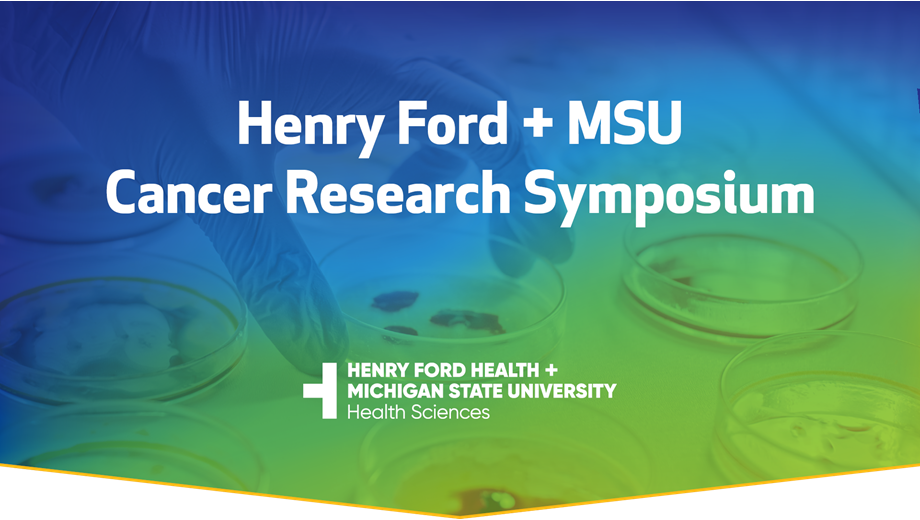
Cancer Symposium Main

4th Annual Henry Ford + MSU Cancer Research Symposium
November 7-8, 2024 | Cambria Hotel Downtown, Detroit MI
For any questions, please contact Manpreet Kaur, mkaur1@hfhs.org.
The Henry Ford + MSU Cancer Research Symposium encourages collaboration and innovation within the scientific and clinical community at Henry Ford Health and Michigan State University (MSU). Established by Henry Ford Health + Michigan State University Health Sciences in 2021, the multidisciplinary cancer symposium features Henry Ford Health and MSU speakers and external keynote presentations on basic, translational, and clinical trials to reduce cancer health disparities.
The theme for this year’s symposium is Maximum Impact: Working Together to Eliminate Cancer in Our Patients and Community.
AGENDA
The symposium will feature Henry Ford + MSU speakers, including opening remarks from Steve Kalkanis, M.D. and Norm Hubbard, as well as an interactive panel discussion with our cancer leadership triad, Jeff MacKeigan, Ph.D., Ben Movsas, M.D. and Derek Raghavan, M.D., Ph.D.
CLICK HERE to view the full agenda for the symposium.
CONTINUING MEDICAL EDUCATION INFORMATION
Michigan State University College of Osteopathic Medicine is accredited by the Accreditation Council for Continuing Medical Education (ACCME) to provide continuing medical education for physicians. MSUCOM designates this live activity for a maximum of 5.5 AMA PRA Category 1 Credit(s)TM.
For any questions related to CME, please contact the College of Osteopathic Medicine CME office at cme@com.msu.edu..
ABSTRACT GUIDELINES AND SUBMISSION
Thank you to everyone who submitted an abstract for the 4th Annual Henry Ford + MSU Cancer Research Symposium.
CLICK HERE to view the abstract booklet for the symposium.
HOTEL ACCOMMODATIONS
Cambria Hotel
600 W Lafayette Blvd., Detroit
BOOK ROOM
